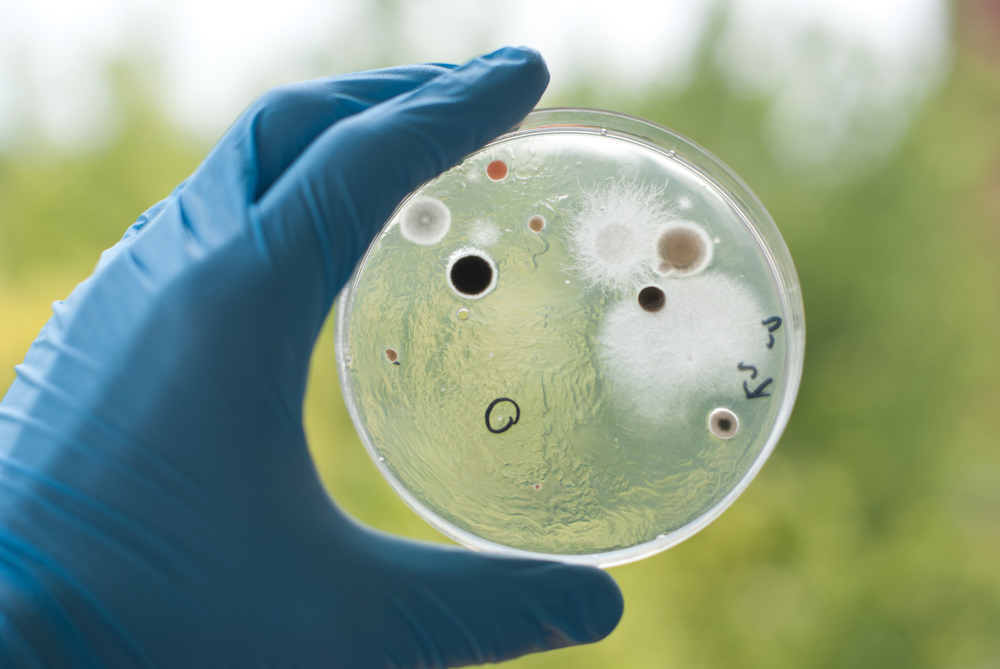

TPC or Coli form or E.Coli or Staph or Salmonella
Objective
Helping the lab analyst to identify coliform ,e-coli, salmonella……etc and how to differentiate between them and how to prepare chemicals which used to distinguish it
Contents
- Discussion of the suitable media for e-coli or coliform or salmonella
- Methods of total plate count
- Isolation, dilution and the confirmatory tests of these bacteria
Training Plan
| Download our Training Plan | 
|